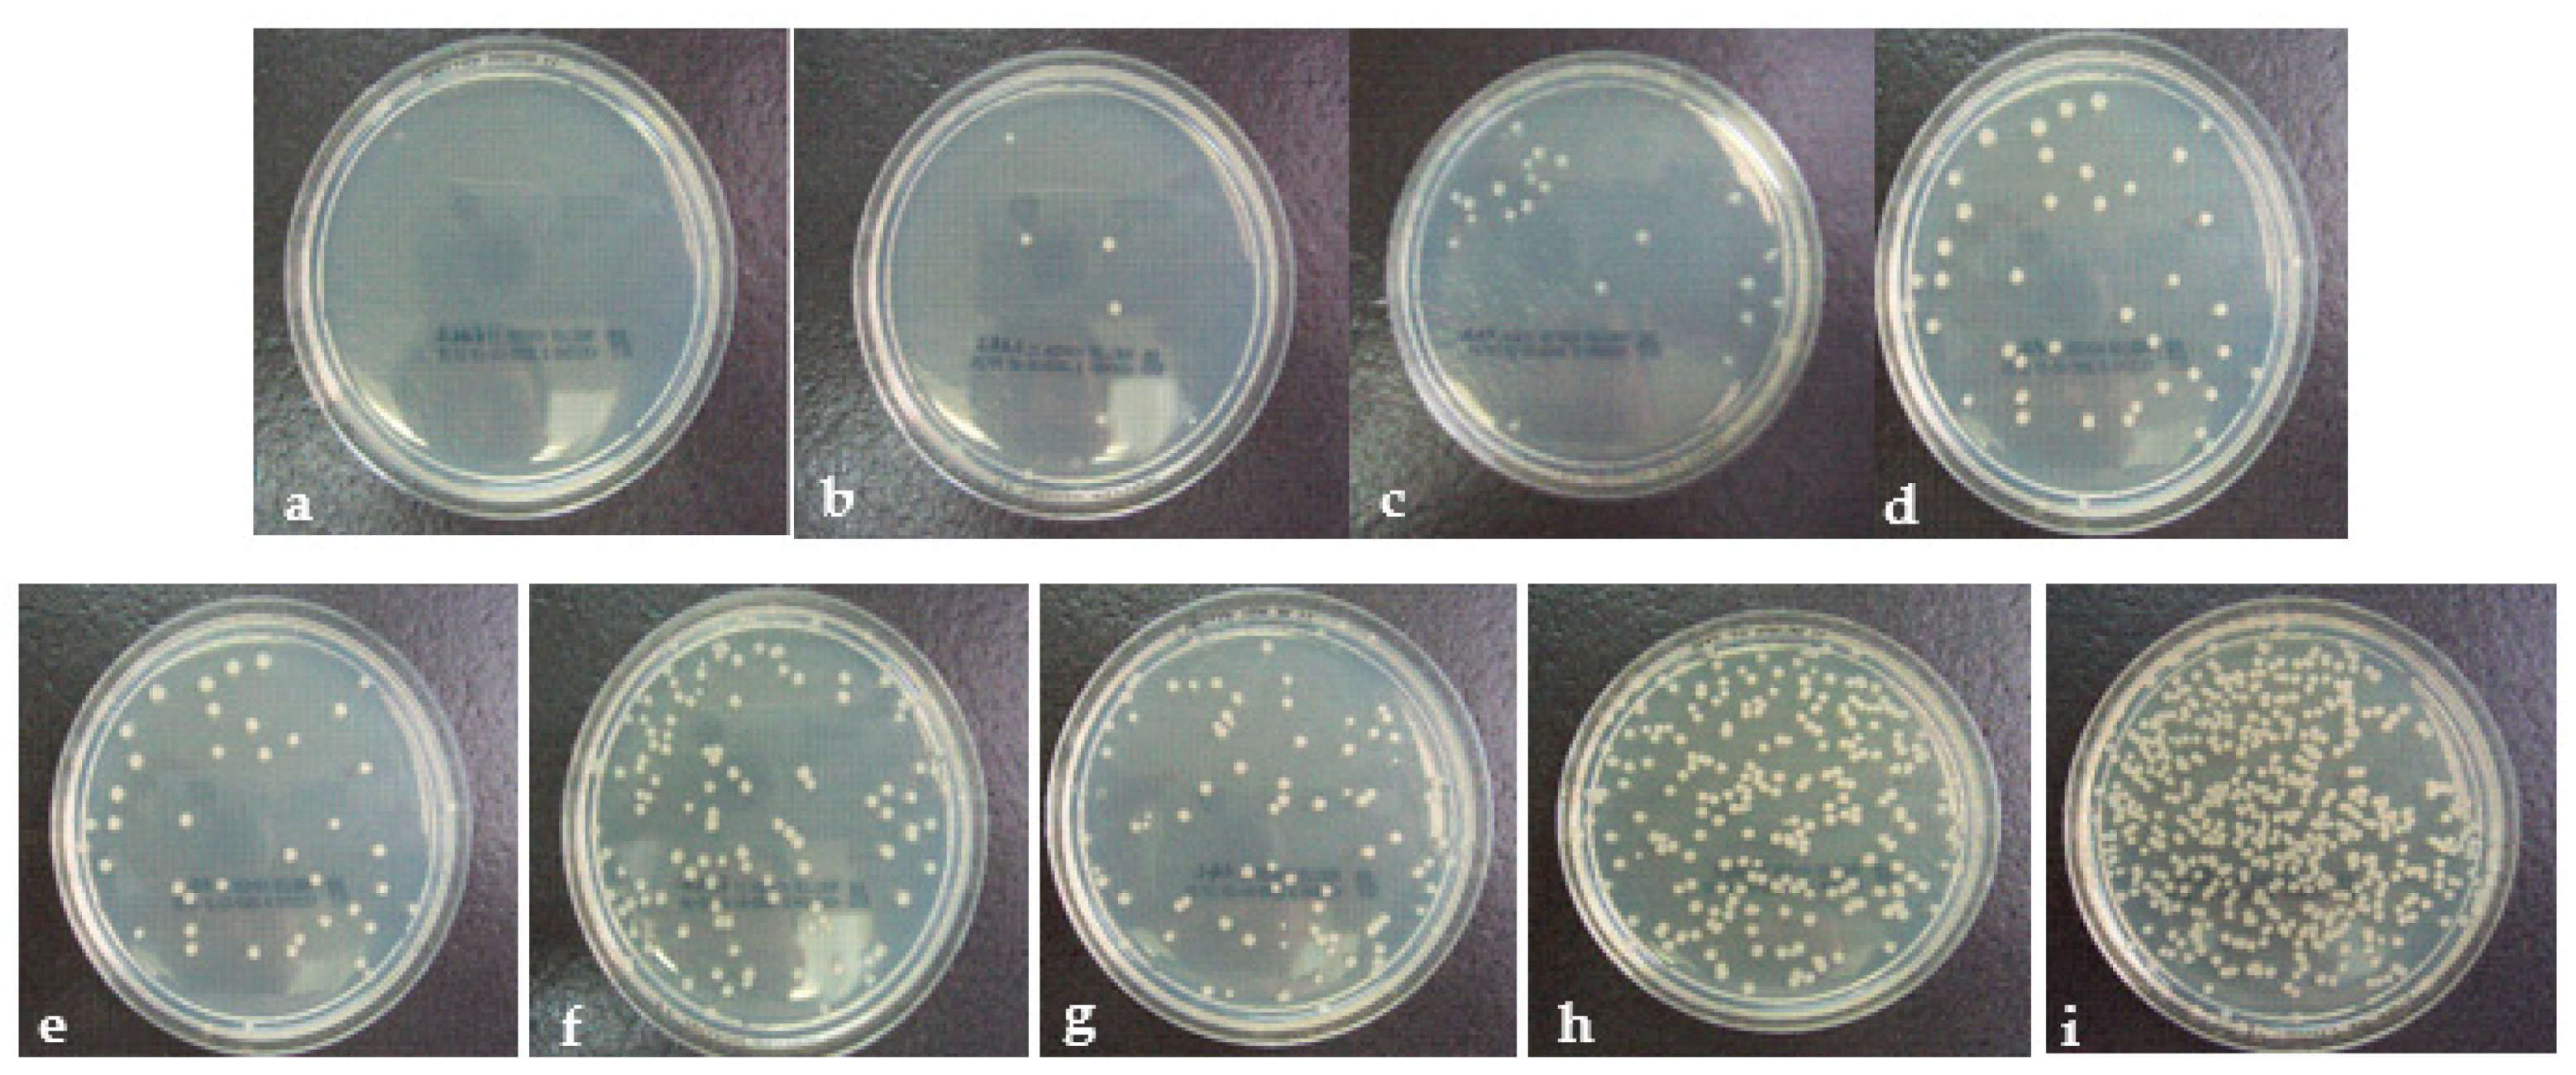
Coatings 11 00102 g007 Coatings 11 00102 g007
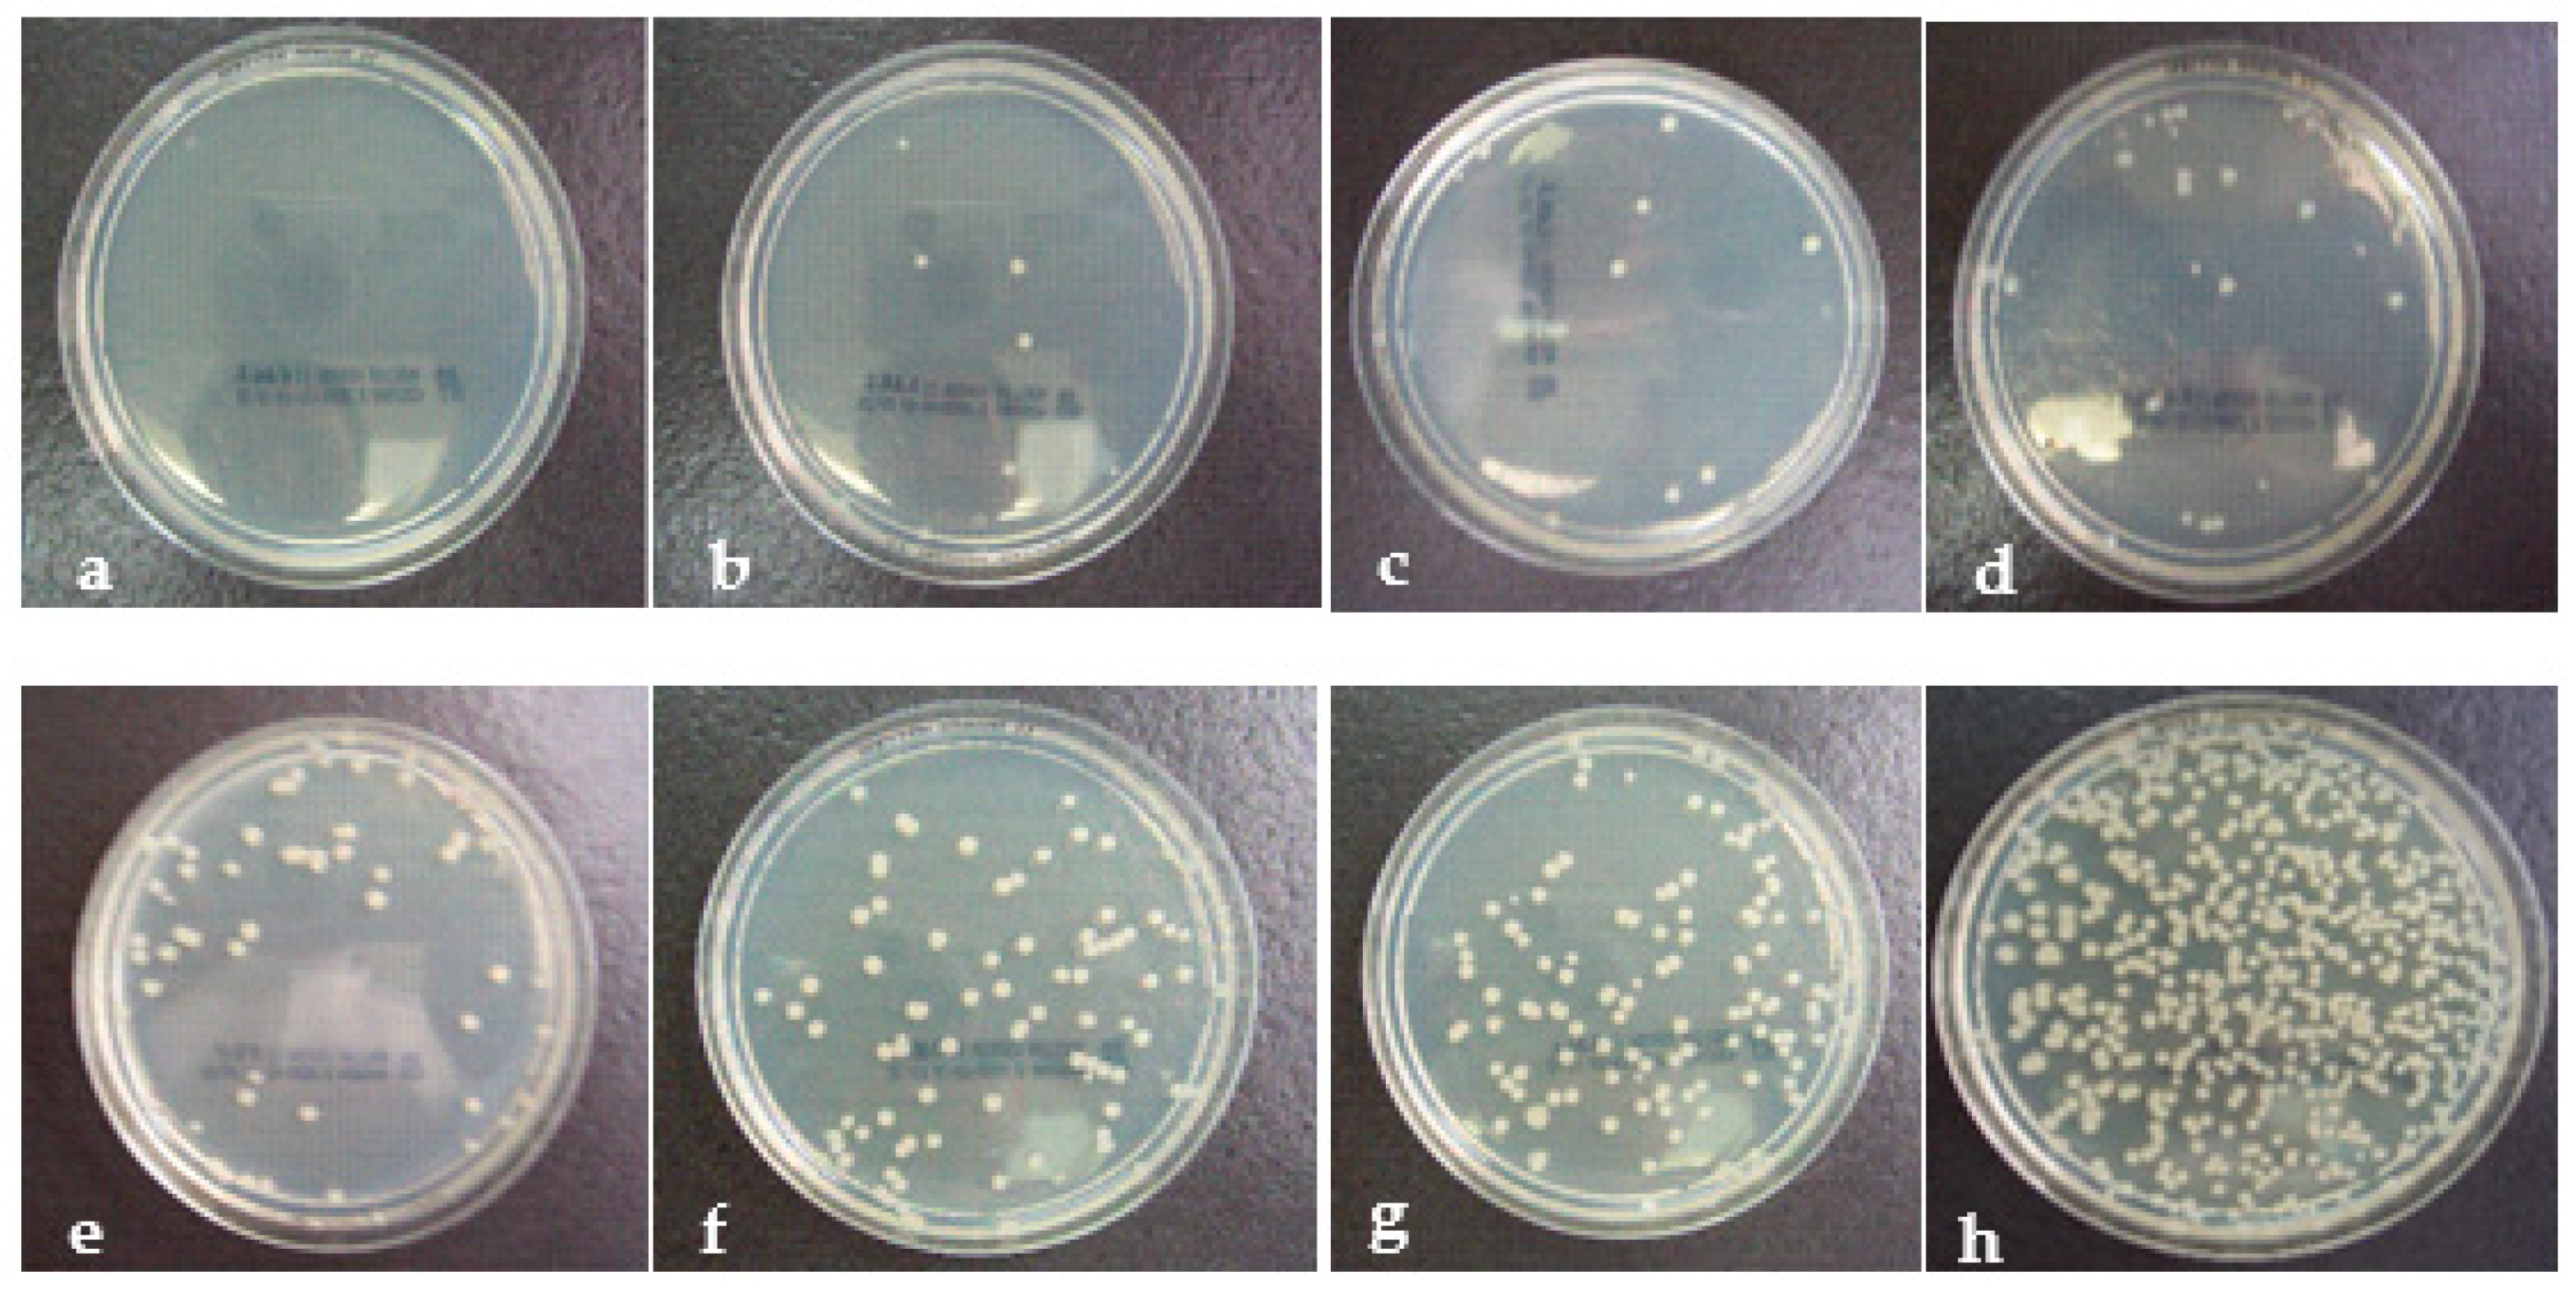
Coatings 11 00102 g009 Coatings 11 00102 g009

Analysis of Surface Properties of Ag and Ti Ion-Treated Medical Textiles by Metal Vapor Vacuum Arc Ion Implantation
Abstract
1. Introduction
2. Experiments
2.1. Ion-Implanted Fabrics
2.2. Nanoparticle-Treated Samples
2.3. Antibacterial Test Procedure
2.4. Laundry Procedure
2.5. Friction Resistance Test
2.6. UV Protection Factor Test
2.7. SEM Analysis
3. Results and Discussion
3.1. Antibacterial Efficiency Results of Cotton Fabrics
3.2. Results of Polyester Fabrics
3.3. In the Case of Higher Ion Doses
3.4. Friction Coefficiency Results of 5 × 1015 Ion/cm2 Titanium Ion-Implanted Polyester Fabric
3.5. UV Protection Factor of 5 × 1015 Ion/cm2 Ag Ion-Implanted Polyester Fabric
4. Conclusions
Funding
Institutional Review Board Statement
Informed Consent Statement
Data Availability Statement
Acknowledgments
Conflicts of Interest
References
- Mejía, M.L.; Zapata, J.; Cuesta, D.P.; Ortiz, I.C.; Botero, L.E.; Galeano, B.J.; Hoyos, L.M. Properties of antibacterial nano textile for use in hospital environments. Revis. Ing. Biomed. 2017, 11, 13–19. [Google Scholar] [CrossRef]
- Morais, D.S.; Guedes, R.M. Antimicrobial approaches for textiles: From research to market. Materials 2016, 9, 498. [Google Scholar] [CrossRef] [PubMed]
- Gokarneshan, N.; Chandrasekar, P.T.; Suvitha, L. Advances in nanotextile finishes—An approach towards sustainability. In Textiles and Clothing Sustainability; Muthu, S., Ed.; Springer: Singapore, 2017; pp. 1–56. [Google Scholar]
- Islam, S.; Shabbir, M.; Mohammad, F. Insights into the functional finishing of textile materials using nanotechnology. In Textiles and Clothing Sustainability; Muthu, S., Ed.; Springer: Singapore, 2017; pp. 97–115. [Google Scholar]
- Krce, L.; Šprung, M.; Maravić, A.; Umek, P.; Salamon, K.; Krstulović, N.; Aviani, I. Bacteria exposed to silver nanoparticles synthesized by laser ablation in water: Modelling E. coli growth and inactivation. Materials 2020, 13, 653. [Google Scholar] [CrossRef] [PubMed]
- Li, J.; He, J.; Huang, Y. Role of alginate in antibacterial finishing of textiles. Int. J. Biol. Macromol. 2017, 94, 466–473. [Google Scholar] [CrossRef] [PubMed]
- Turakhia, B.; Divakara, M.B.; Santosh, M.S.; Shah, S. Green synthesis of copper oxide nanoparticles: A promising approach in the development of antibacterial textiles. J. Coat. Technol. Res. 2020, 17, 531–540. [Google Scholar] [CrossRef]
- Zemljič, L.F.; Peršin, Z.; Šauperl, O.; Rudolf, A.; Kostić, M. Medical textiles based on viscose rayon fabrics coated with chitosan-encapsulated iodine: Antibacterial and antioxidant properties. Text. Res. J. 2018, 88, 2519–2531. [Google Scholar]
- Fouda, A.; Saad, E.L.; Salem, S.S.; Shaheen, T.I. In-vitro cytotoxicity, antibacterial, and UV protection properties of the biosynthesized zinc oxide nanoparticles for medical textile applications. Microb. Pathog. 2018, 125, 252–261. [Google Scholar] [CrossRef]
- Ouadil, B.; Amadine, O.; Essamlali, Y.; Cherkaoui, O.; Zahouily, M. A new route for the preparation of hydrophobic and antibacterial textiles fabrics using Ag-loaded graphene nanocomposite. Colloids Surf. 2019, 579, 123713. [Google Scholar] [CrossRef]
- Edgetech. Ion Implantation. Available online: https://www.edge-techind.com/category/Ion-implantation-44-1.html (accessed on 17 January 2021).
- IBAD Lab. IBAD Laboratory. Available online: https://fyzika.fs.cvut.cz/laboratorIBADEN.php (accessed on 17 January 2021).
- Öktem, T.; Özdogan, E.; Namligöz, S.E.; Öztarhan, A.; Tek, Z.; Tarakçioglu, I.; Karaaslan, A. Investigating the applicability of metal ion implantation technique (MEVVA) to textile surfaces. Text. Res. J. 2006, 76, 32–40. [Google Scholar]
- Öktem, T.; Tarakcıoğlu, I.; Özdoğan, E.; Öztarhan, A.; Namlıgöz, E.S.; Karaaslan, A.; Tek, Z. Modification of friction and wear properties of PET membrane fabrics by MEVVA ion implantation. Mat. Chem. Phys. 2008, 108, 208–213. [Google Scholar]
- Nikolaev, A.G.; Yushkov, G.Y.; Oks, E.M.; Oztarhan, A.; Akpek, A.; Hames-Kocabas, E.; Urkac, E.S.; Brown, I.G. Modification of anti-bacterial surface properties of textile polymers by vacuum arc ion source implantation. Appl. Surf. Sci. 2014, 310, 51–55. [Google Scholar] [CrossRef]
- Anna, K.; Mateusz, S.; Eva., K. Similarities and differences between silver ions and silver in nanoforms as antibacterial agents. Int. J. Mol. Sci. 2018, 19, 444. [Google Scholar]
- Alavi, M.; Rai, M. Recent advances in antibacterial applications of metal nanoparticles (MNPs) and metal nanocomposites (MNCs) against multidrug-resistant (MDR) bacteria. Expert Rev. Anti-Infect. 2019, 17, 419–428. [Google Scholar] [CrossRef]
- Ward, L.P.; Purushotham, K.P.; Manory, R.R. MEVVA ion implantation of TiCN coatings; structural and tribological properties. Nucl. Instrum. Methods Phys. Res. Sect. 2019, 449, 40–48. [Google Scholar] [CrossRef]
- Wang, C.C.; Chen, C.C. Physical properties of crosslinked cellulose catalyzed with nano titanium dioxide. J. Appl. Polym. Sci. 2005, 97, 2450–2456. [Google Scholar] [CrossRef]
- Vaishya, R.; Agarwal, A.K.; Tiwari, M.; Vaish, A.; Vijay, V.; Nigam, Y. Medical textiles in orthopedics: An overview. J. Clin. Orthop. Trauma 2018, 9, S26–S33. [Google Scholar] [CrossRef] [PubMed]
- Ward, L.P.; Purushotham, K.P.; Manory, R.R. Nuclear instruments and methods in physics research B studies on the surface modification of TiN coatings using MEVVA ion implantation with selected metallic species. Nucl. Insturm. Methods Phys. Res. 2016, 368, 37–44. [Google Scholar] [CrossRef]
- Dastjerdi, R.; Montazer, M. A review on the application of inorganic nano-structured materials in the modification of textiles: Focus on anti-microbial properties. Coll. Surf. 2010, 79, 5–18. [Google Scholar] [CrossRef]
- Yuranova, T.; Rincon, A.G.; Pulgarin, C.; Laub, D.; Xantopoulos, N.; Mathieu, H.J.; Kiwi, J. Performance and characterization of Ag-cotton and Ag/TiO2 loaded textiles during the abatement of E. coli. J. Photochem. Photobiol. 2006, 181, 363–369. [Google Scholar] [CrossRef]
- AATCC Test Method 100-1999, Assessment of Antibacterial Finishes on Textile Materials; AATCC: Research Triangle Park, NC, USA, 1999.
- AATCC 124-2006, Test Method Appearance of Fabrics After Repeated Home Laundering; AATCC: Research Triangle Park, NC, USA, 2006.
- ASTM D4157-13, Standard Test Method for Abrasion Resistance of Textile Fabrics (Oscillatory Cylinder Method); ASTM International: West Conshohocken, PA, USA, 2013.
- Öztarhan, A.; Akpek, A.; Oks, E.; Nikolaev, A. Modifying medical textiles with antibacterial and friction resistance abilities by an alternative nanotextile technology called ion implantation technique. In Proceedings of the 2010 15th National Biomedical Engineering Meeting, Antalya, Turkey, 21–24 April 2010; pp. 1–4. [Google Scholar]
- Menter, J.M.; Hatch, K.L. Clothing as solar radiation protection. Curr. Probl. Derm. 2003, 31, 50–63. [Google Scholar]
- AATCC 183:2014, Test Method for Transmittance or Blocking of Erythemally Weighted Ultraviolet Radiation through Fabrics; AATCC: Research Triangle Park, NC, USA, 2014.
- Öztarhan, A.; Akpek, A.; Oks, E.; Nikolaev, A. Modifying textiles with antibacterial effect, friction resistance, UV protection and electrostatic charge decay abilities by an alternative nanotextile technology called MEVVA ion implantation technique. In Proceedings of the VIth Nanoscience and Nanotechnology Conference (NANOTR), Izmir, Turkey, 15–18 June 2010. [Google Scholar]
- Nikolaev, A.G.; Savkin, K.P.; Yushkov, G.Y.; Oks, E.M.; Oztarhan, A.; Akpek, A.; Cireli, I. Modification of the textile materials by vacuum arc ion source implantation. In Proceedings of the 10th International Conference on Modification of Materials with Particle Beams and Plasma Flows (10th CMM), Tomsk, Rusya, 19–24 September 2010; pp. 401–404. [Google Scholar]
- Buras, E.M., Jr.; Goldthwait, C.F.; Kraemer, R.M. Measurement and theory of absorbency of cotton fabrics. Text. Res. J. 1950, 20, 239–248. [Google Scholar] [CrossRef]
- Nayfeh, M.H. (Ed.) Delivery of nanoparticles on surfaces. In Fundamentals and Applications of Nano Silicon in Plasmonics and Fullerines: Current and Future Trends; Elsevier: Amsterdam, The Netherlands, 2018; pp. 341–362. [Google Scholar]
- Koçak, O.; Kurtuldu, H.; Akpek, A.; Koçoğlu, A.; Eroğul, O. A medical waste management model for public private partnership hospitals. In Proceedings of the 2016 Medical Technologies National Congress (TIPTEKNO), Antalya, Turkey, 27–29 October 2016; pp. 1–4. [Google Scholar]

| No. | Antibacterial Agent (Cathode) | Fabric Type | Ion/cm2 (Dose) |
|---|---|---|---|
| I1 | Ag | Cotton | 5 × 1015 |
| I2 | Ag | Cotton | 5 × 1016 |
| I3 | Ag | Polyester | 5 × 1016 |
| I4 | Ag | Polyester | 5 × 1015 |
| I5 | TiO2 | Cotton | 5 × 1016 |
| I6 | TiO2 | Cotton | 5 × 1015 |
| I7 | TiO2 | Polyester | 5 × 1016 |
| I8 | TiO2 | Polyester | 5 × 1015 |
| Sample No. | Antibacterial Agent | Sample Type |
|---|---|---|
| N1 | Ag | Cotton |
| N2 | TiO2 | Polyester |
| N3 | TiO2 | Cotton |
| N4 | Ag | Cotton |
| N5 | Ag | Polyester |
| No. | Ion/cm2 (Dose) (Cathode) | Fabric Type | Antibacterial Agent |
|---|---|---|---|
| I1 | 5 × 1015 | Cotton | Ag |
| I4 | 5 × 1015 | Polyester | Ag |
| I6 | 5 × 1015 | Cotton | TiO2 |
| I8 | 5 × 1015 | Polyester | TiO2 |
| I5 | 5 × 1016 | Cotton | TiO2 |
| I3 | 5 × 1016 | Polyester | Ag |
| I7 | 5 × 1016 | Polyester | TiO2 |
| I2 | 5 × 1016 | Cotton | Ag |
| UV Protection Factor | Protection Standard |
|---|---|
| 15–24 | Good Protection |
| 25–39 | Very Good Protection |
| 40–50, 50+ | Excellent Protection |
Publisher’s Note: MDPI stays neutral with regard to jurisdictional claims in published maps and institutional affiliations. |
© 2021 by the author. Licensee MDPI, Basel, Switzerland. This article is an open access article distributed under the terms and conditions of the Creative Commons Attribution (CC BY) license (http://creativecommons.org/licenses/by/4.0/).
Share and Cite
Akpek, A. Analysis of Surface Properties of Ag and Ti Ion-Treated Medical Textiles by Metal Vapor Vacuum Arc Ion Implantation. Coatings 2021, 11, 102. https://doi.org/10.3390/coatings11010102
Akpek A. Analysis of Surface Properties of Ag and Ti Ion-Treated Medical Textiles by Metal Vapor Vacuum Arc Ion Implantation. Coatings. 2021; 11(1):102. https://doi.org/10.3390/coatings11010102
Chicago/Turabian StyleAkpek, Ali. 2021. "Analysis of Surface Properties of Ag and Ti Ion-Treated Medical Textiles by Metal Vapor Vacuum Arc Ion Implantation" Coatings 11, no. 1: 102. https://doi.org/10.3390/coatings11010102
APA StyleAkpek, A. (2021). Analysis of Surface Properties of Ag and Ti Ion-Treated Medical Textiles by Metal Vapor Vacuum Arc Ion Implantation. Coatings, 11(1), 102. https://doi.org/10.3390/coatings11010102

